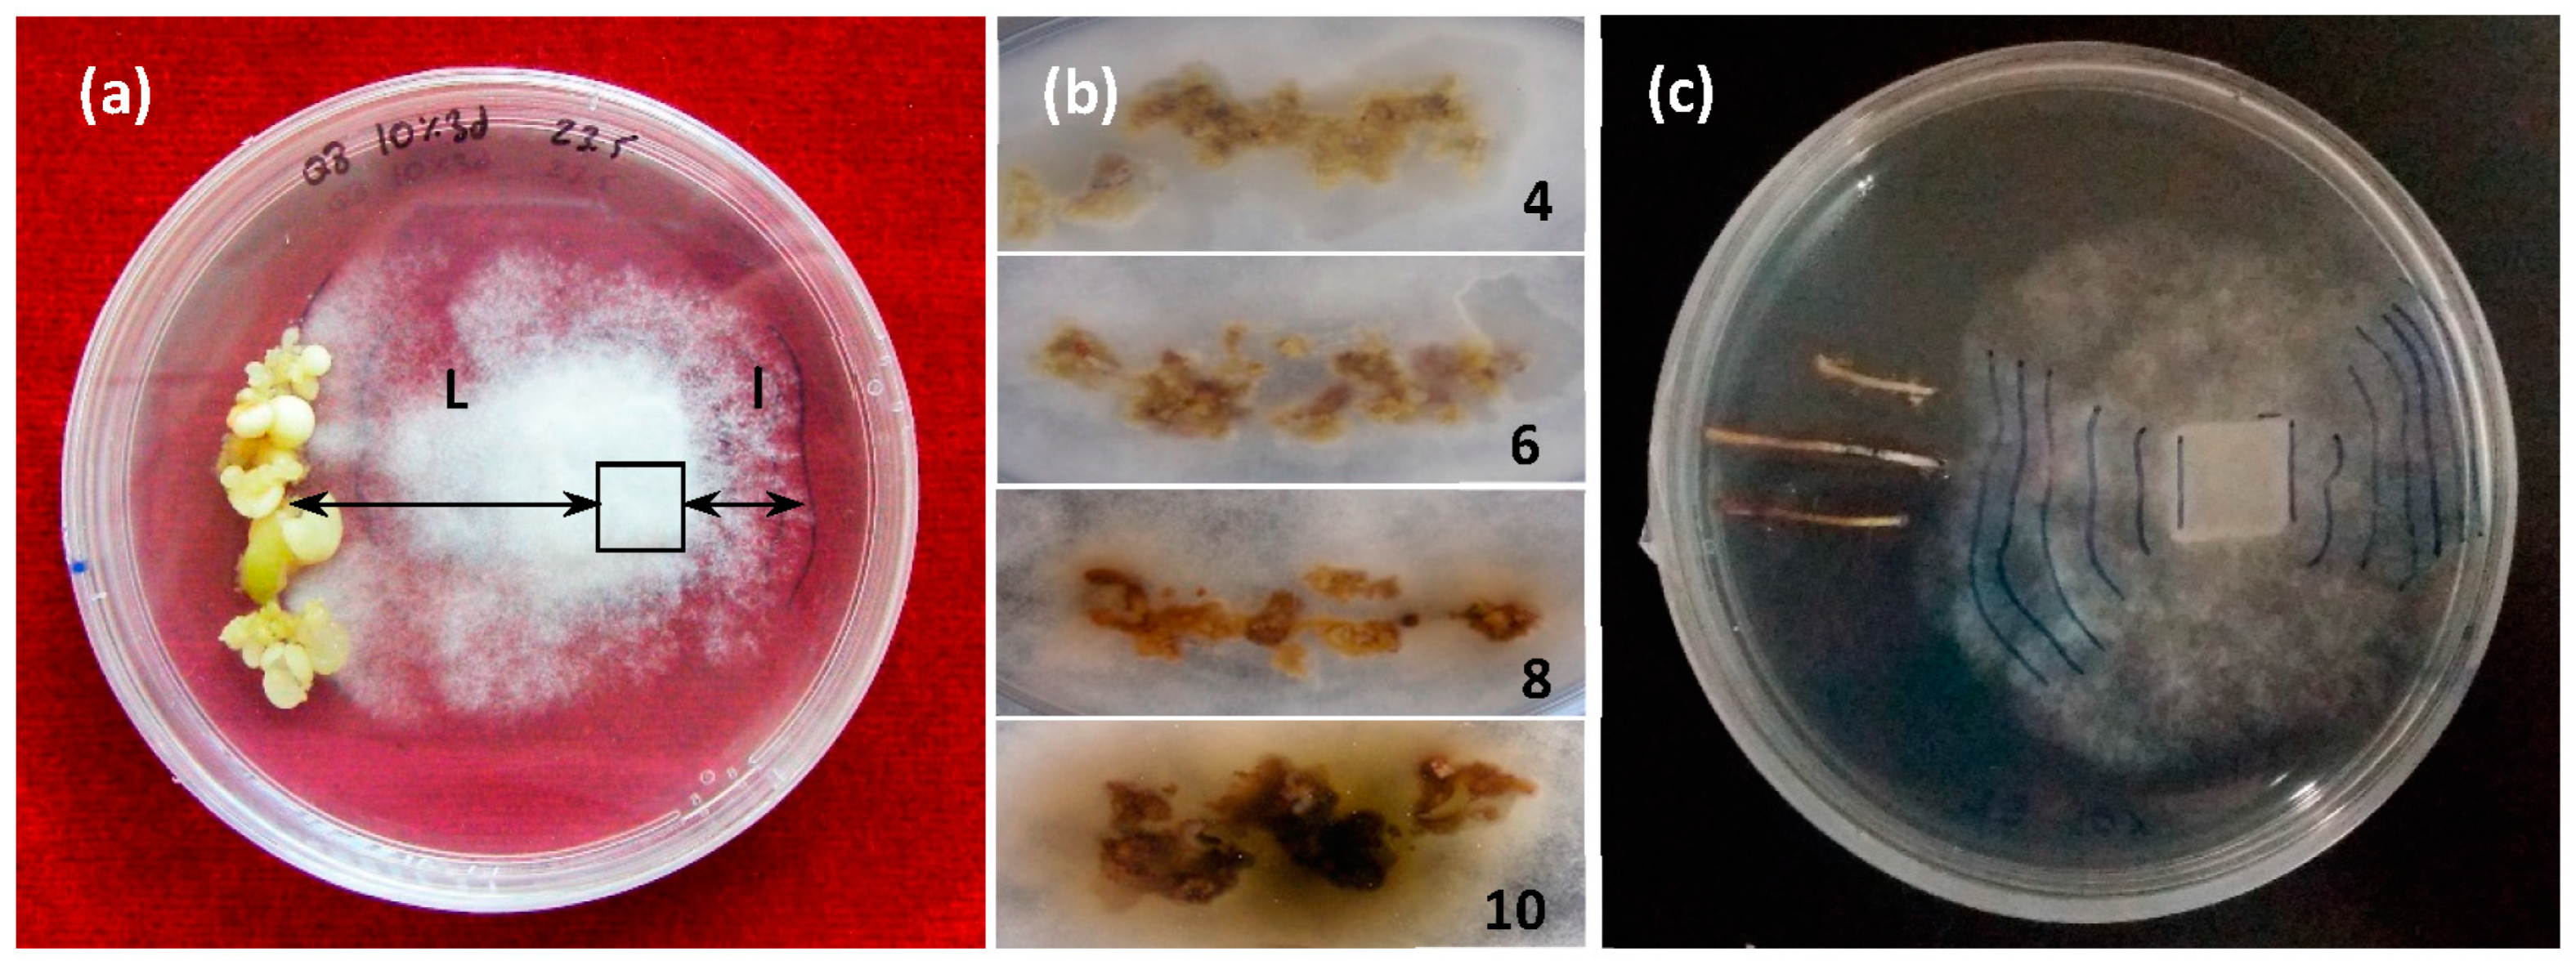

Tolerant Epitypes of Elicited Holm Oak Somatic Embryos Could Be Revealed by Challenges in Dual Culture with Phytophthora cinnamomi Rands
Abstract
1. Introduction
2. Results
2.1. Multiplication Rate of Biomass and Production of Elicited Somatic Embryos
2.2. Dual Culture Assays with Elicited Somatic Embryos
2.3. Dual Culture Assays with Roots from Elicited Somatic Embryos
2.4. Dual Culture Results with Elicited and Naturally Tolerant Holm Oak Somatic Embryos
3. Discussion
3.1. Differential Growth Measurements
3.2. Progress of Necrosis
3.3. Tolerant Epitypes of Elicited Holm Oak Somatic Embryos Could Be Revealed by Challenges in Dual Culture with Phytophthora cinnamomi
4. Materials and Methods
4.1. Somatic Embryos
4.2. Elicitation Media
4.3. Elicitation Treatments
4.4. Dual Culture Assays with P. cinnamomi
4.5. Comparison of Elicited and Tolerant Genotypes When Challenged to Oomycete
4.6. Statistics
5. Conclusions
Author Contributions
Funding
Acknowledgments
Conflicts of Interest
Appendix A
| Summary of All Effects; Design: (ne3d-60d.sta) | ||||||
|---|---|---|---|---|---|---|
| 1—time of elicitation, 2—genotype, 3—elicitor type | ||||||
| df | MS | df | MS | |||
| Effect | Effect | Error | Error | F | p-level | |
| 1 | 1 | 31.7863 | 280 | 8.958084 | 3.54833 | 0.060641 |
| 2 | 2 | 188.1156 | 280 | 8.958084 | 20.99953 | 0.000000 |
| 3 | 6 | 19.2633 | 280 | 8.958084 | 2.15038 | 0.047995 |
| 1 × 2 | 2 | 34.3162 | 280 | 8.958084 | 3.83075 | 0.022839 |
| 1 × 3 | 6 | 15.1410 | 280 | 8.958084 | 1.69021 | 0.123283 |
| 2 × 3 | 12 | 17.6312 | 280 | 8.958084 | 1.96819 | 0.027093 |
| 1 × 2 × 3 | 12 | 9.5778 | 280 | 8.958084 | 1.06918 | 0.386186 |
| ANOVA short-term: 1—genotype, 2—elicitor type | ||||||
| df | MS | df | MS | |||
| Effect | Effect | Error | Error | F | p-level | |
| 1 | 2 | 112.9985 | 129 | 9.799785 | 11.53071 | 0.000025 |
| 2 | 6 | 6.7539 | 129 | 9.799785 | 0.68919 | 0.658701 |
| 1 × 2 | 12 | 13.2595 | 129 | 9.799785 | 1.35304 | 0.197036 |
| ANOVA long-term: 1—genotype, 2—elicitor type | ||||||
| df | MS | df | MS | |||
| Effect | Effect | Error | Error | F | p-level | |
| 1 | 2 | 215.8265 | 301 | 9.968856 | 21.65008 | 0.000000 |
| 2 | 6 | 29.8715 | 301 | 9.968856 | 2.99648 | 0.007379 |
| 1 × 2 | 12 | 17.7308 | 301 | 9.968856 | 1.77862 | 0.050969 |
| DGM SE Day4 | ||||||
|---|---|---|---|---|---|---|
| Post Hoc. Homogeneous Subsets. Duncan | ||||||
| ELICITOR | N | Subconjunt | ||||
| 1 | 2 | 3 | 4 | 5 | ||
| BTH 100 μM | 3 | 0.0000 | ||||
| BTH 50 μM | 5 | 0.4600 | 0.4600 | |||
| BABA 50 μM | 9 | 0.4667 | 0.4667 | |||
| BABA 100 μM | 9 | 0.4889 | 0.4889 | |||
| FILT10 | 5 | 0.7600 | 0.7600 | |||
| SA 50 μM | 4 | 0.7750 | 0.7750 | |||
| FILT30 | 6 | 0.8333 | 0.8333 | 0.8333 | ||
| MeJA 50 μM | 6 | 1.0500 | 1.0500 | 1.0500 | ||
| MeJA 100 μM | 6 | 1.3000 | 1.3000 | 1.3000 | ||
| SA100 μM | 7 | 1.3429 | 1.3429 | |||
| NT | 10 | 1.4400 | ||||
| Treatment | Elicitor | Data of Mean Necrosis on Day | ||
|---|---|---|---|---|
| 5 d (0 h) | 6 d (24 h) | 7 d (48 h) | ||
| Short-term | NT Control | 5.0 ± 0.6 a | 6.8 ± 0.6 a | 8.3 ± 0.8 c |
| MeJA | 4.0 ± 0.3 ab | 6.2 ± 0.4 a | 7.0 ± 0.7 b | |
| BTH | 3.3 ± 0.4 b | 6.8 ± 0.3 a | 8.8 ± 0.2 c | |
| BABA | 3.8 ± 0.3 b | 5.7 ± 0.4 a | 6.7 ± 0.5 b | |
| SA | 5.0 ± 0.3 a | 6.7 ± 0.3 a | 6.7 ± 0.7 b | |
| FILT10 | 4.7 ± 0.3 a | 5.8 ± 0.5 a | 6.7 ± 0.4 b | |
| FILT30 | 4.5 ± 0.3 a | 6.3 ± 0.5 a | 8.1 ± 0.4 bc | |
| GENOTYPE p-level | 0.726371 | 0.026985 | 0.000434 | |
| ELICITOR p-level | 0.009521 | 0.205269 | 0.000522 | |
| GENOT.x ELICIT. p-level | 0.193688 | 0.005282 | 0.000004 | |
| Long-term | NT Control | 4.1 ± 0.4 ab | 6.1 ± 0.5 a | 9.1 ± 0.4 b |
| MeJA | 4.5 ± 0.4 a | 7.1 ± 0.3 a | 9.4 ± 0.4 b | |
| BTH | 3.5 ± 0.2 ab | 6.2 ± 0.3 a | 7.0± 0.3 a | |
| BABA | 4.5 ± 0.4 ab | 6.3 ± 0.5 a | 9.8 ± 0.1 b | |
| SA | 4.4 ±0.4 ab | 6.1 ± 0.5 a | 9.4 ± 0.3 b | |
| FILT10 | 3.6 ± 0.3 ab | 4.8 ± 0.4 b | 7.4 ± 0.7 a | |
| FILT30 | 3.3 ± 0.4 b | 4.6 ± 0.5 b | 7.8 ± 0.9 a | |
| GENOTYPE p-level | 0.010112 | 0.000000 | 0.616524 | |
| ELICITOR p-level | 0.007692 | 0.000000 | 0.000000 | |
| GENOT.x ELICIT. p-level | 0.112587 | 0.048975 | 0.010868 | |
| Short-term all factors | 4.3 ± 0.1 a | 6.3 ± 0.2 a | 7.4 ± 0.2 a | |
| Long-term all factors | 3.7 ± 0.2 b | 5.6 ± 0.3 b | 8.5 ± 0.2 b | |
| TREATMENT TIME, p-level | 0.043759 | 0.028627 | 0.000301 | |
| Elicitor | Short Elicitation | Long Elicitation | ||||||||||
|---|---|---|---|---|---|---|---|---|---|---|---|---|
| Q8 | E2 | E00 | Q8 | E2 | E00 | |||||||
| N | % | N | % | N | % | N | % | N | % | N | % | |
| NT | 45 | 24.44 | 0 | - | 10 | 0.00 | 50 | 38.00 | 22 | 9.09 | 10 | 10.00 |
| MeJa | 17 | 5.88 | 17 | 0.00 | 10 | 0.00 | 20 | 35.00 | 21 | 19.05 | 10 | 10.00 |
| BTH | 36 | 22.22 | 0 | - | 0 | - | 0 | - | 0 | - | 0 | - |
| BABA | 43 | 9.30 | 0 | - | 10 | 0.00 | 29 | 31.03 | 28 | 32.14 | 9 | 11.11 |
| SA | 21 | 9.52 | 6 | 0.00 | 10 | 0.00 | 20 | 45.00 | 10 | 20 | 9 | 0.00 |
| FILT30 | 48 | 8.33 | 0 | - | 32 | 0.00 | 34 | 20.59 | 7 | 0.00 | 4 | 0.00 |
| FILT10 | 19 | 5.26 | 0 | - | 25 | 8.00 | 46 | 34.78 | 6 | 0.00 | 10 | 10.00 |
References
- Terradas, J. Holm Oak and Holm Oak Forests: An Introduction. In Ecology of Mediterranean Evergreen Oak Forests; Rodà, F., Retana, J., Gracia, C.A., Bellot, J., Eds.; Ecological Studies; Springer: Berlin/Heidelberg, Germany, 1999; Volume 137. [Google Scholar] [CrossRef]
- Macháčová, M.; Nakládal, O.; Samek, M.; Baťa, D.; Zumr, V.; Pešková, V. Oak Decline Caused by Biotic and Abiotic Factors in Central Europe: A Case Study from the Czech Republic. Forests 2022, 13, 1223. [Google Scholar] [CrossRef]
- Serrano, M.S.; Romero, M.; Homet, P.; Gómez-Aparicio, L. Climate change impact on the population dynamics of exotic pathogens: The case of the worldwide pathogen Phytophthora cinnamomi. Agric. For. Meteorol. 2022, 322, 109002. [Google Scholar] [CrossRef]
- Camilo-Alves, C.S.P.; da Clara, M.I.E.; de Almeida Ribeiro, N.M.C. Decline of Mediterranean oak trees and its association with Phytophthora cinnamomi: A review. Eur. J. For. Res. 2013, 132, 411–432. [Google Scholar] [CrossRef]
- Duque-Lazo, J.; Navarro-Cerrillo, R.M.; van Gils, H.; Groen, T.A. Forecasting oak decline caused by Phytophthora cinnamomi in Andalusia: Identification of priority areas for intervention. For. Ecol. Manag. 2018, 417, 122–136. [Google Scholar] [CrossRef]
- Gómez, F.J.R.; Navarro-Cerrillo, R.M.; Pérez-De-Luque, A.; Oβwald, W.; Vannini, A.; Morales-Rodríguez, C. Assessment of functional and structural changes of soil fungal and oomycete communities in holm oak declined dehesas through metabarcoding analysis. Sci. Rep. 2019, 9, 5315. [Google Scholar] [CrossRef]
- Cardillo, E.; Acedo, A.; Abad, E. Topographic effects on dispersal patterns of Phytophthora cinnamomi at a stand scale in a Spanish heathland. PLoS ONE 2018, 13, e0195060. [Google Scholar] [CrossRef]
- Rodríguez-Romero, M.; Cardillo, E.; Santiago, R.; Pulido, F. Susceptibility to Phytophthora cinnamomi of six holm oak (Quercus ilex) provenances: Are results under controlled vs. natural conditions consistent. For. Syst. 2022, 31, e011. [Google Scholar] [CrossRef]
- San-Eufrasio, B.; Castillejo, M.; Labella-Ortega, M.; Ruiz-Gómez, F.J.; Navarro-Cerrillo, R.M.; Tienda-Parrilla, M.; Jorrín-Novo, J.V.; Rey, M.D. Effect and response of Quercus ilex subsp. ballota [Desf.] Samp. Seedlings from three contrasting Andalusian populations to individual and combined Phytophthora cinnamomi and drought stresses. Front. Plant Sci. 2021, 12, 722802. [Google Scholar] [CrossRef]
- Salgotra, R.K.; Chauhan, B.S. Genetic Diversity. Conservation and utilization of plant genetic resources. Genes 2023, 14, 174. [Google Scholar] [CrossRef]
- Lebedev, V.G.; Lebedeva, T.N.; Chernodubov, A.I.; Shestibratov, K.A. Genomic selection for forest tree improvement: Methods, achievements and perspectives. Forests 2020, 11, 1190. [Google Scholar] [CrossRef]
- Zamorano, J.P.; Hernández, I.; Ávila, A.; Cardillo, E.; Ruiz-Galea, M. Guía Para la Selección. Micropropagación y Evaluación de Alcornoques Resistentes a Phytophthora cinnamomi; Agrícola-Henar Comunicación: Madrid, Spain, 2023; ISBN 978-84-17884-29-1. [Google Scholar]
- Martínez, M.T.; Arrillaga, I.; Sales, E.; Pérez-Oliver, M.A.; González-Mas, M.d.C.; Corredoira, E. Micropropagation, characterization and conservation of Phytophthora cinnamomi-tolerant holm oak mature trees. Forests 2021, 12, 1634. [Google Scholar] [CrossRef]
- Martínez, M.T.; San-José, M.D.C.; Arrillaga, I.; Cano, V.; Morcillo, M.; Cernadas, M.J.; Corredoira, E. Holm oak somatic embryogenesis: Current status and future perspectives. Front. Plant Sci. 2019, 10, 239. [Google Scholar] [CrossRef] [PubMed]
- Morcillo, M.; Sales, E.; Ponce, L.; Guillén, A.; Segura, J.; Arrillaga, I. Effect of elicitors on holm oak somatic embryo development and efficacy inducing tolerance to Phytophthora cinnamomi. Sci. Rep. 2020, 10, 15166. [Google Scholar] [CrossRef]
- Morcillo, M.; Sales, E.; Corredoira, E.; Martínez, M.T.; Segura, J.; Arrillaga, I. Effect of methyl-jasmonate in gene expression and in hormonal and phenolic profiles of holm oak embryogenic lines before and after infection with Phytophthora cinnamomi. Front. Plant Sci. 2022, 13, 824781. [Google Scholar] [CrossRef] [PubMed]
- Ashapkin, V.V.; Kutueva, L.I.; Aleksandrushkina, N.I.; Vanyushin, B.F. Epigenetic mechanisms of plant adaptation to biotic and abiotic stresses. Int. J. Mol. Sci. 2020, 21, 7457. [Google Scholar] [CrossRef] [PubMed]
- Holeski, L.M.; Jander, G.; Agrawal, A.A. Transgenerational defense induction and epigenetic inheritance in plants. Trends Ecol. Evol. 2012, 27, 618–626. [Google Scholar] [CrossRef] [PubMed]
- Rajpal, V.R.; Rathore, P.; Mehta, S. Epigenetic variation: A major player in facilitating plant fitness under changing environmental conditions. Front. Cell Dev. Biol. 2022, 10, 1020958. [Google Scholar] [CrossRef]
- Conrath, U. Systemic acquired resistance. Plant Signal. Behav. 2006, 1, 179–184. [Google Scholar] [CrossRef]
- Muthamilarasan, M.; Prasad, M. Plant innate immunity: An updated insight into defense mechanism. J. Biosci. 2013, 38, 433–449. [Google Scholar] [CrossRef]
- Vivas, M.; Hernández, J.; Corcobado, T.; Cubera, E.; Solla, A. Transgenerational induction of resistance to Phytophthora cinnamomi in Holm Oak. Forests 2021, 12, 100. [Google Scholar] [CrossRef]
- Yakovlev, I.; Fossdal, C.G.; Skrøppa, T.; Olsen, J.E.; Jahren, A.H.; Johnsen, O. An adaptive epigenetic memory in conifers with important implications for seed production. Seed Sci. Res. 2012, 22, 63–76. [Google Scholar] [CrossRef]
- Ono, A.; Kinoshita, T. Epigenetics and plant reproduction: Multiple steps for responsibly handling succession. Curr. Opin. Plant Biol. 2021, 61, 102032. [Google Scholar] [CrossRef]
- Barra-Jiménez, A.; Blasco, M.; Ruiz-Galea, M.; Celestino, C.; Alegre, J.; Arrillaga, I.; Toribio, M. Cloning mature holm oak trees by somatic embryogenesis. Trees 2014, 28, 657–667. [Google Scholar] [CrossRef]
- Worrall, D.; Holroyd, G.H.; Moore, J.P.; Glowacz, M.; Croft, P.; Taylor, J.E.; Paul, N.D.; Roberts, M.R. Treating seeds with activators of plant defence generates long-lasting priming of resistance to pests and pathogens. New Phytol. 2012, 193, 770–778. [Google Scholar] [CrossRef] [PubMed]
- Yang, Z.; Zhi, P.; Chang, C. Priming seeds for the future: Plant immune memory and application in crop protection. Front. Plant Sci. 2022, 13, 961840. [Google Scholar] [CrossRef] [PubMed]
- Kharel, A.; Islam, M.T.; Rookes, J.; Cahill, D. How to unravel the key functions of cryptic oomycete elicitin proteins and their role in plant disease. Plants 2021, 10, 1201. [Google Scholar] [CrossRef] [PubMed]
- Cravador, A.; Horta, M.; Caetano, P.; Medeira, C.L.; Maia, I. Involvement of the β-cinnamomin elicitin in infection and colonisation of cork oak roots by Phytophthora cinnamomi. Eur. J. Plant Pathol. 2010, 127, 427–436. [Google Scholar]
- Ebadzad, G.; Medeira, C.L.; Maia, I.; Martin, J.; Cravador, A. Induction of defence responses by cinnamomins against Phytophthora cinnamomi in Quercus suber and Quercus ilex subs. Rotundifolia. Eur. J. Plant Pathol. 2015, 143, 705–723. [Google Scholar] [CrossRef]
- Meenakshi, T.; Baldev, S.S. Role of Elicitors in inducing resistance in plants against pathogen infection: A Review. ISRN Biochem. 2013, 2013, 762412. [Google Scholar] [CrossRef]
- Ganesan, M.; Jayabalan, N. Isolation of disease-tolerant cotton (Gossypium hirsutum L. cv. SVPR 2) plants by screening somatic embryos; with fungal culture filtrate. Plant Cell Tissue Organ Cult. 2006, 87, 273–284. [Google Scholar] [CrossRef]
- Jayasankar, S.; Li, Z.; Gray, D.J. In-vitro selection of Vitis vinifera ‘Chardonnay’ with Elsinoe ampelina culture filtrate is accompanied by fungal resistance and enhanced secretion of chitinase. Planta 2000, 211, 200–208. [Google Scholar] [CrossRef] [PubMed]
- Svábová, L.; Lebeda, A. In Vitro selection for improved plant resistance to toxin-producing pathogens. J. Phytopathol. 2005, 153, 52–64. [Google Scholar] [CrossRef]
- Flores, P.S.; Otoni, W.C.; Dhingra, O.D.; de Souza-Diniz, S.P.S.; Dos-Santos, T.M.; Bruckner, C.H. In vitro selection of yellow passion fruit genotypes for resistance to Fusarium vascular wilt. Plant Cell Tissue Organ Cult. 2012, 108, 37–45. [Google Scholar] [CrossRef]
- Nawrot-Chorabik, K. The use of interactions in dual cultures in vitro to evaluate the pathogenicity of fungi and susceptibility of host plant genotypes. In Environmental Biotechnology—New Approaches and Prospective Applications; Intech Open Science Publisher: Rijeka, Croatia, 2013; pp. 287–301. [Google Scholar] [CrossRef]
- Nawrot-Chorabik, K. Interactions between embryogenic callus of Abies alba and Heterobasidion spp. in dual cultures. Biol. Plant 2014, 58, 363–369. [Google Scholar] [CrossRef]
- Nawrot-Chorabik, K.; Grad, B.; Kowalski, T. Interactions between callus cultures of Pinus sylvestris and pine fungi with different trophic properties. For. Pathol. 2016, 46, 179–186. [Google Scholar] [CrossRef]
- Oßwald, W.; Fleischmann, F.; Rigling, D.; Coelho, A.C.; Cravador, A.; Diez, J.; Dalio, R.J.; Jung, M.H.; Pfanz, H.; Robin, C.; et al. Strategies of attack and defence in woody plant—Phytophthora interactions. For. Pathol. 2014, 44, 169–190. [Google Scholar] [CrossRef]
- Kvaalen, H.; Johnsen, O. Timing of bud set in Picea abies is regulated by a memory of temperature during zygotic and somatic embryogenesis. New Phytol. 2008, 177, 49–59. [Google Scholar] [CrossRef]
- Castander-Olarieta, A.; Pereira, C.; Sales, E.; Meijón, M.; Arrillaga, I.; Cañal, M.J.; Goicoa, T.; Ugarte, M.D.; Moncaleán, P.; Montalbán, I.A. Induction of radiata pine somatic embryogenesis at high temperatures provokes a long-term decrease in DNA methylation/hydroxymethylation and differential expression of stress-related genes. Plants 2020, 9, 1762. [Google Scholar] [CrossRef]
- Sales, E.; Cañizares, E.; Pereira, C.; Pérez-Oliver, M.A.; Nebauer, S.G.; Pavlović, I.; Novák, O.; Segura, J.; Arrillaga, I. Changing temperature conditions during somatic embryo maturation result in Pinus pinaster plants with altered response to heat stress. Int. J. Mol. Sci. 2022, 23, 1318. [Google Scholar] [CrossRef]
- Ramírez-Estrada, K.; Vidal-Limon, H.; Hidalgo, D.; Moyano, E.; Golenioswki, M.; Cusidó, R.M.; Palazon, J. Elicitation, an effective strategy for the biotechnological production of bioactive high-added value compounds in plant cell factories. Molecules 2016, 21, 182. [Google Scholar] [CrossRef]
- Jiménez, J.A.; Alonso-Blázquez, N.; López-Vela, D.; Celestino, C.; Toribio, M.; Alegre, J. Influence of culture vessel characteristics and agitation rate on gaseous exchange, hydrodynamic stress and growth of embryogenic cork oak (Quercus suber L.) cultures. In Vitro Cell. Dev. Biol. Plant 2011, 47, 578–588. [Google Scholar] [CrossRef]
- Yu, X.; Zhang, W.; Zhang, Y.; Zhang, X.; Lang, D. The roles of methyl-jasmonate to stress in plants. Funct. Plant Biol. 2019, 46, 197–212. [Google Scholar] [CrossRef] [PubMed]
- Elhiti, M.; Stasolla, C. Transduction of Signals during Somatic Embryogenesis. Plants 2022, 11, 178. [Google Scholar] [CrossRef] [PubMed]
- Mira, M.; Wally, O.; Elhiti, M. Jasmonic acid is a downstream component in the modulation of somatic embryogenesis by Arabidopsis Class 2 phytoglobin. J. Exp. Bot. 2016, 67, 2231–2246. [Google Scholar] [CrossRef] [PubMed]
- Rodríguez-Romero, M.; Gallardo, A.; Pulido, F. Geographical and within-population variation of constitutive chemical defences in a Mediterranean oak (Quercus ilex). For. Syst. 2020, 29, e011. [Google Scholar] [CrossRef]
- Toby, J.A.B. Variation in plant responsiveness to defence elicitors caused by genotype and environment. Front. Plant Sci. 2014, 5, 349. [Google Scholar] [CrossRef][Green Version]
- Ren, X.; Wang, J.; Zhu, F.; Wang, Z.; Mei, J.; Xie, Y.; Liu, T.; Ye, X. β-aminobutyric acid (BABA)-induced resistance to tobacco black shank in tobacco (Nicotiana tabacum L.). PLoS ONE 2022, 17, e0267960. [Google Scholar] [CrossRef]
- Catoni, M.; Alvarez-Venegas, R.; Worrall, D.; Holroyd, G.; Barraza, A.; Luna, E.; Ton, J.; Roberts, M.R. Long-lasting defence priming by β-aminobutyric acid in tomato is marked by genome-wide changes in DNA Methylation. Front. Plant Sci. 2022, 13, 836326. [Google Scholar] [CrossRef]
- Janotík, A.; Dadáková, K.; Lochman, J.; Zapletalová, M. L-Aspartate and L-Glutamine inhibit beta-aminobutyric acid-induced resistance in tomatoes. Plants 2022, 11, 2908. [Google Scholar] [CrossRef]
- Cooper, A.; Ton, J. Immune priming in plants: From the onset to transgenerational maintenance. Essays Biochem. 2022, 66, 635–646. [Google Scholar] [CrossRef]
- Zimmerli, L.; Jakab, G.; Métraux, J.P.; Mauch-Mani, B. Potentiation of pathogen-specific defense mechanisms in Arabidopsis by β-aminobutyric acid. Proc. Natl. Acad. Sci. USA 2000, 97, 12920–12925. [Google Scholar] [CrossRef] [PubMed]
- Ton, J.; Jakab, G.; Toquin, V.; Flors, V.; Iavicoli, A.; Maeder, M.N.; Métraux, J.P.; Mauch-Mani, B. Dissecting the beta-aminobutyric acid-induced priming phenomenon in Arabidopsis. Plant Cell 2005, 17, 987–999. [Google Scholar] [CrossRef]
- Zhang, Y.; Xu, S.; Ding, P.; Wang, D.; Cheng, Y.T.; He, J.; Gao, M.; Xu, F.; Li, Y.; Zhu, Z.; et al. Control of salicylic acid synthesis and systemic acquired resistance by two members of a plant-specific family of transcription factors. Proc. Natl. Acad. Sci. USA 2010, 107, 18220–18225. [Google Scholar] [CrossRef] [PubMed]
- Berg, N.v.D.; Swart, V.; Backer, R.; Fick, A.; Wienk, R.; Engelbrecht, J.; Prabhu, S.A. Advances in understanding defense mechanisms in Persea americana against Phytophthora cinnamomi. Front. Plant Sci. 2021, 12, 636339. [Google Scholar] [CrossRef] [PubMed]
- Botha, T.; Wehner, F.C.; Kotzé, J.M. An evaluation of in vitro screening techniques for determining tolerance of avocado rootstocks to Phytophthora cinnamomi. South Afr. Avocado Grow. Assoc. Yearb. 1989, 12, 60–63. [Google Scholar]
- Van der Merwe, M.D.V. An improved method to evaluate avocado rootstocks for resistance to Phytophthora cinnamomi. South Afr. Avocado Grow. Assoc. Yearb. 1990, 13, 67–68. [Google Scholar]
- Guo, J.; Cheng, Y. Advances in fungal elicitor-triggered plant immunity. Int. J. Mol. Sci. 2022, 23, 12003. [Google Scholar] [CrossRef]
- Backer, R.; Engelbrecht, J.; and van den Berg, N. Differing responses to Phytophthora cinnamomi infection in susceptible and partially resistant Persea americana (Mill.) Rootstocks: A case for the role of receptor-like kinases and apoplastic proteases. Front Plant Sci. 2022, 13, 928176. [Google Scholar] [CrossRef]
- Midgley, K.A.; van den Berg, N.; Swart, V. Unraveling plant cell death during Phytophthora Infection. Microorganisms 2022, 10, 1139. [Google Scholar] [CrossRef]
- Saiz-Fernández, I.; Đorđević, B.; Kerchev, P.; Černý, M.; Jung, T.; Berka, M.; Fu, C.H.; Horta Jung, M.; Brzobohatý, B. Differences in the proteomic and metabolomic response of Quercus suber and Quercus variabilis during the early stages of Phytophthora cinnamomi infection. Front. Microbiol. 2022, 13, 894533. [Google Scholar] [CrossRef]
- Schenk, R.U.; Hildebrandt, A.C. Medium and techniques for induction and growth of monocotyledonous and dicotyledonous plant cell cultures. Can. J. Bot. 1972, 50, 199–204. [Google Scholar] [CrossRef]
- Murashige, T.; Skoog, F.A. Revised medium for rapid growth and bio assays with tobacco tissue cultures. Physiol. Plant. 1962, 15, 473–497. [Google Scholar] [CrossRef]
- Corcobado, T.; Solla, A.; Madeira, M.A.; Moreno, G. Combined effects of soil properties and Phytophthora cinnamomi infections on Quercus ilex decline. Plant Soil 2013, 373, 403–413. [Google Scholar] [CrossRef]

| Elicitor | Short-Term Elicitation (3 Days) | Long-Term Elicitation (60 Days) | ||||||||||
|---|---|---|---|---|---|---|---|---|---|---|---|---|
| Q8 | E2 | E00 | Q8 | E2 | E00 | |||||||
| MR | SE | MR | SE | MR | SE | MR | SE | MR | SE | MR | SE | |
| NT | 1.8 | 5.2 ± 1.4 a | 1.6 | 0.0 ± 0.0 a | 2.3 | 3.0 ± 0.3 a | 2.4 | 7.7 ± 1.0 b | 3.0 | 3.0 ± 0.8 b | 1.8 | 3.7 ± 0.4 b |
| MeJA | 1.5 | 3.5 ± 1.1 a | 1.0 | 4.6 ± 1.4 b | 1.5 | 3.6 ± 1.1 a | 3.0 | 5.6 ± 1.0 b | 2.4 | 6.0 ± 1.2 b | 2.0 | 2.0 ± 0.6 ab |
| BTH | 2.5 | 5.0 ± 1.9 a | 0.2 | 0.0 ± 0.0 a | 2.0 | 4.2 ± 2.5 a | 1.8 | 0.4 ± 0.2 a | 2.2 | 0.4 ± 0.2 a | 1.0 | 0.6 ± 0.4 a |
| BABA | 1.7 | 5.7 ± 0.6 a | 1.6 | 0.4 ± 0.3 a | 2.0 | 2.7 ± 1.8 a | 2.8 | 6.5 ± 1.0 b | 2.8 | 5.0 ± 1.2 b | 2.4 | 2.3 ± 0.7 ab |
| SA | 2.0 | 6.8 ± 2.3 a | 0.8 | 1.0 ± 0.7 a | 2.0 | 4.3 ± 1.0 a | 2.4 | 2.9 ± 1.1 b | 2.4 | 2.6 ± 0.8 b | 0.8 | 3.3 ± 0.8 b |
| FILT30 | 1.7 | 5.9 ± 1.7 a | 1.4 | 0.0 ± 0.0 a | 1.5 | 3.4 ± 0.8 a | 2.4 | 4.2 ± 0.9 b | 1.2 | 3.3 ± 1.1 b | 0.4 | 4.0 ± 0.0 b |
| FILT10 | 1.7 | 2.6 ± 0.7 a | 1.6 | 0.0 ± 0.0 a | 2.0 | 3.1 ± 1.0 a | 1.6 | 4.7 ± 0.9 b | 1.8 | 1.3 ± 0.7 ab | 0.2 | 3.5 ± 0.5 b |
| Genotype | DGM (cm). Short-Term Treatment | DGM (cm). Long-Term Treatment | |||||||
|---|---|---|---|---|---|---|---|---|---|
| Day2 | Day3 | Day4 | Day5 | Day2 | Day3 | Day4 | Day5 | Day6 | |
| Control | 0.0 ± 0.0 a | 0.5 ± 0.3 a | 0.5 ± 0.4 a | 0.5 ± 0.8 a | 0.2 ± 0.3 a | 0.1 ± 0.4 a | 0.1 ± 0.5 a | 0.3 ± 0.5 a | 0.7 ± 0.5 a |
| Q8 | 0.0 ± 1.0 a | 2.5 ± 0.9 a | 2.8 ± 0.5 b | 0.7 ± 0.6 a | 2.2 ± 0.4 b | 4.4 ± 0.7 b | 9.6 ± 1.3 b | 17.2 ± 1.3 b | 23.4 ± 1.4 b |
| E00 | 0.8 ± 0.5 a | 3.7 ± 1.2 b | 4.8 ± 0.9 c | 2.0 ± 1.3 a | 0.2 ± 0.5 a | 4.3 ± 1.0 b | 8.9 ± 1.3 b | 14.4 ± 1.7 b | 19.8 ± 1.3 c |
| E2 | - | - | - | - | 1.3 ± 0.2 b | 5.0 ± 0.6 b | 10.2± 1.2 b | 16.8 ± 1.6 b | 22.1± 0.5 bc |
Disclaimer/Publisher’s Note: The statements, opinions and data contained in all publications are solely those of the individual author(s) and contributor(s) and not of MDPI and/or the editor(s). MDPI and/or the editor(s) disclaim responsibility for any injury to people or property resulting from any ideas, methods, instructions or products referred to in the content. |
© 2023 by the authors. Licensee MDPI, Basel, Switzerland. This article is an open access article distributed under the terms and conditions of the Creative Commons Attribution (CC BY) license (https://creativecommons.org/licenses/by/4.0/).
Share and Cite
Ruiz-Galea, M.; Kremer, C.; Friero, E.; Hernández, I. Tolerant Epitypes of Elicited Holm Oak Somatic Embryos Could Be Revealed by Challenges in Dual Culture with Phytophthora cinnamomi Rands. Plants 2023, 12, 3056. https://doi.org/10.3390/plants12173056
Ruiz-Galea M, Kremer C, Friero E, Hernández I. Tolerant Epitypes of Elicited Holm Oak Somatic Embryos Could Be Revealed by Challenges in Dual Culture with Phytophthora cinnamomi Rands. Plants. 2023; 12(17):3056. https://doi.org/10.3390/plants12173056
Chicago/Turabian StyleRuiz-Galea, Mar, Carolina Kremer, Eva Friero, and Inmaculada Hernández. 2023. "Tolerant Epitypes of Elicited Holm Oak Somatic Embryos Could Be Revealed by Challenges in Dual Culture with Phytophthora cinnamomi Rands" Plants 12, no. 17: 3056. https://doi.org/10.3390/plants12173056
APA StyleRuiz-Galea, M., Kremer, C., Friero, E., & Hernández, I. (2023). Tolerant Epitypes of Elicited Holm Oak Somatic Embryos Could Be Revealed by Challenges in Dual Culture with Phytophthora cinnamomi Rands. Plants, 12(17), 3056. https://doi.org/10.3390/plants12173056

